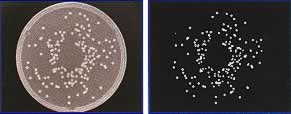

| 画像距離測定計測ソフト/品番 M1128VS-9Z |
【詳細表示】
|
| 商品番号 |
M1128VS-9Z |
価 格
|
 |
2値化自動計測
手動計測
OK/NGを自動判定
フィルタ処理により画像改善
さまざまな計測を標準装備
計測結果をCSV保存 |
画像距離測定計測ソフト
品番 M1128VS-9Z
廃番 |
■誰でも使える画像計測ソフト
●導入のための時間とコスト
せっかく顕微鏡があるのだから、その画像を使って計測したい。
測定結果を製品に添えることで、製品の信頼度を向上させたい。
研究・開発部門だけではなく、生産現場に導入したいがソフトの扱い方を勉強している時間がない。
●すぐ使える・誰でも使いこなせる。
そんな現場の方の声にお応えしてつくられました、とても「あつかいやすい」画像計測ソフトです。
ご導入頂いたその日の内に、パソコンが苦手な方でも、どなたでも使いこなせる、そんなソフトを目指して開発致しま
した。
■ソフトに詳しくならなくても操作可能なインターフェイス
大きなボタンでユーザーフレンドリーなインターフェイス設計なので、初めて操作される方にも分かりやすく、直感的な
操作が可能。
どなたでも簡単にお使い頂けます。
■便利な処理が一度に行える簡単設定!
いろいろな処理がひとつのダイアログボックスで行えるので、計測対象の設定が簡単に行えます。
なんども処理を設定する必要がないので、慣れない方でもスムーズに解析が行えます。

■2値化自動計測
本器を使えば、2値化による自動計測を簡単に行えます。
画像処理を初めて行う方にも理解し易い構成でも導入もスムーズ。
検査・検品業務のコストダウンにお役だちます。

■選択領域をマスク表示
計測したい箇所を選択する際に、選択領域もしくは非選択領域に半透明なマスクをかけて表示することが出来るの
で、狙った箇所を確実に選択できます。

■ON/NG判定を自動計算
あらかじめ基準値を設定しておけば、OK/NGの判定を自動で行えます。
検査・検品の時間を大幅に短縮可能です。

■判定を数値化できる
画像処理の手順を定めることで、良品、不良品の判定を数値化することができます。
これによって検査担当者ごとの結果のバラつきなどを防ぐことができます。

■計測事例
■2値化とは
計測したい画像から、計測したい箇所を抽出するときに、計測したい箇所を白、それ以外の箇所を黒に分離させる操
作を2値化といいます。
■明るさで抽出
計測したい箇所を、それ以外と箇所との明るさの違いで抽出することができます。
通常のデジタル画像は明るさ情報を256段階で表示していますので、指定のしきい値以上の明るさを持つ部分だけ
を指定します。
■色で抽出
計測したい箇所を、それ以外と箇所との色の違いで抽出することができます。
近似値を指定することで、似た色の部分も同時に指定することができます。
■バリエーションに富んだ手動計測
2点間距離や半径・直径のほか、ドーナツ型面積や、中線距離、多点距離の平均の自動算出など、バリエーションに
富んだ2次元計測機能を標準装備・最初からさまざまな計測方法に対応しておりますので、必要な計測結果を簡単
に手にすることが出来ます。

| 垂線距離 |
頂点角度/直径 |
 |
 |
| ドーナツ型面積・距離 |
中線間距離 |
 |
 |
■その他の特徴
●100種類の倍率登録が可能
画像撮影の際のレンズ倍率ごとのキャリブレーション値をレンズ10種類×10の倍率=100種類登録可能です。
一度倍率を登録すればいつでも呼び出せるのでスムーズな解析が可能です。
●画素レベルで計測可能
デジタルズームと手動計測機能のスムーズな連動で、より正確な端点を指定しての計測が可能です。
保存してる過去の画像の再計測も可能です。

●計測結果をCSV保存
得られた計測結果は、画像上に書き込むほか、CSV形式で保存することができます。
表計算ソフトなどへの計測結果の移植が簡単に行えます。
●コメント入力
画像上にコメントを書き込むことが出来るので、見ただけで分かる、分かりやすい報告書の作成が可能です。

●フィルタ処理による画像改善
多彩なフィルタ処理によって、計測しやすい画像を得るための画像改善機能も充実。
より正確な計測を行うためにお役立ちます。

●処理方法を記録
一度決めた処理方法を記録・保存しておくことが出来ますので、同じ製品の判定を何度も行う際などに便利です。
■必要なシステム
| OS |
Windows XP/2000/Vista |
| CPU |
Pentium 以上推奨 |
| メインメモリ |
128MB以上推奨 |
| ハードディスク |
空き容量 20MB以上 |
| 解像度 |
1024×768 以上推奨 |
| ハードウェア |
DOS/V 機 |
|